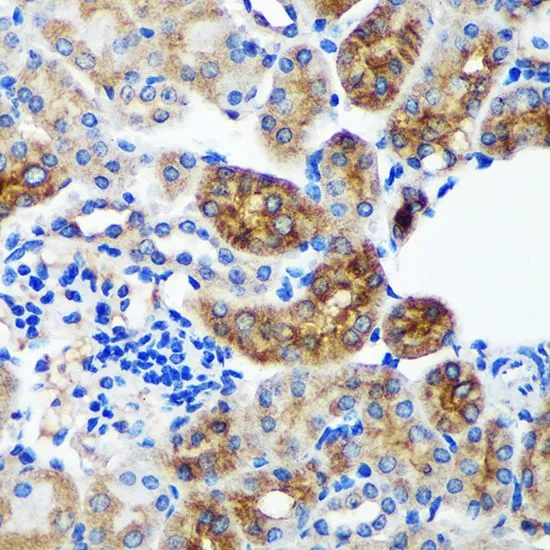
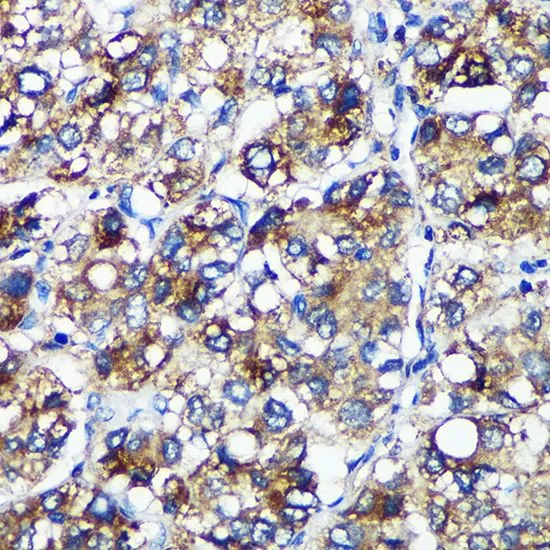

ICC/IF analysis of C6 cells using GTX66340 PYCR2 antibody. Blue : DAPI Dilution : 1:100
PYCR2 antibody
GTX66340
ApplicationsImmunoFluorescence, Western Blot, ImmunoCytoChemistry, ImmunoHistoChemistry, ImmunoHistoChemistry Paraffin
Product group Antibodies
ReactivityHuman, Mouse, Rat
TargetPYCR2
Overview
- SupplierGeneTex
- Product NamePYCR2 antibody
- Delivery Days Customer9
- Application Supplier NoteWB: 1:500 - 1:2000. ICC/IF: 1:50 - 1:200. IHC-P: 1:50 - 1:200. *Optimal dilutions/concentrations should be determined by the researcher.Not tested in other applications.
- ApplicationsImmunoFluorescence, Western Blot, ImmunoCytoChemistry, ImmunoHistoChemistry, ImmunoHistoChemistry Paraffin
- CertificationResearch Use Only
- ClonalityPolyclonal
- ConjugateUnconjugated
- Gene ID29920
- Target namePYCR2
- Target descriptionpyrroline-5-carboxylate reductase 2
- Target synonymsHLD10, P5CR2, pyrroline-5-carboxylate reductase 2, P5C reductase 2, pyrroline-5-carboxylate reductase family member 2
- HostRabbit
- IsotypeIgG
- Protein IDQ96C36
- Protein NamePyrroline-5-carboxylate reductase 2
- Scientific DescriptionThis gene belongs to the pyrroline-5-carboxylate reductase family. The encoded mitochondrial protein catalyzes the conversion of pyrroline-5-carboxylate to proline, which is the last step in proline biosynthesis. Alternatively spliced transcript variants have been described for this gene. [provided by RefSeq, Nov 2012]
- ReactivityHuman, Mouse, Rat
- Storage Instruction-20°C or -80°C,2°C to 8°C
- UNSPSC41116161

![WB analysis of HEK293T cells transfected with PYCR2 plasmid (Right) or empty vector (Left) for 48 hrs using GTX83752 PYCR2 antibody [4A10]. Loading : 5 ug per lane](https://www.genetex.com/upload/website/prouct_img/normal/GTX83752/GTX83752_3879_WB_w_23061420_467.webp)
![FACS analysis of HeLa cells using GTX83753 PYCR2 antibody [2A5]. Red : Primary antibody Blue : Negative control antibody](https://www.genetex.com/upload/website/prouct_img/normal/GTX83753/GTX83753_169_FACS_w_23061420_965.webp)
![WB analysis of various cell lines using GTX83754 PYCR2 antibody [2F11]. Loading : 35 ug per lane](https://www.genetex.com/upload/website/prouct_img/normal/GTX83754/GTX83754_3884_WB_w_23061420_529.webp)